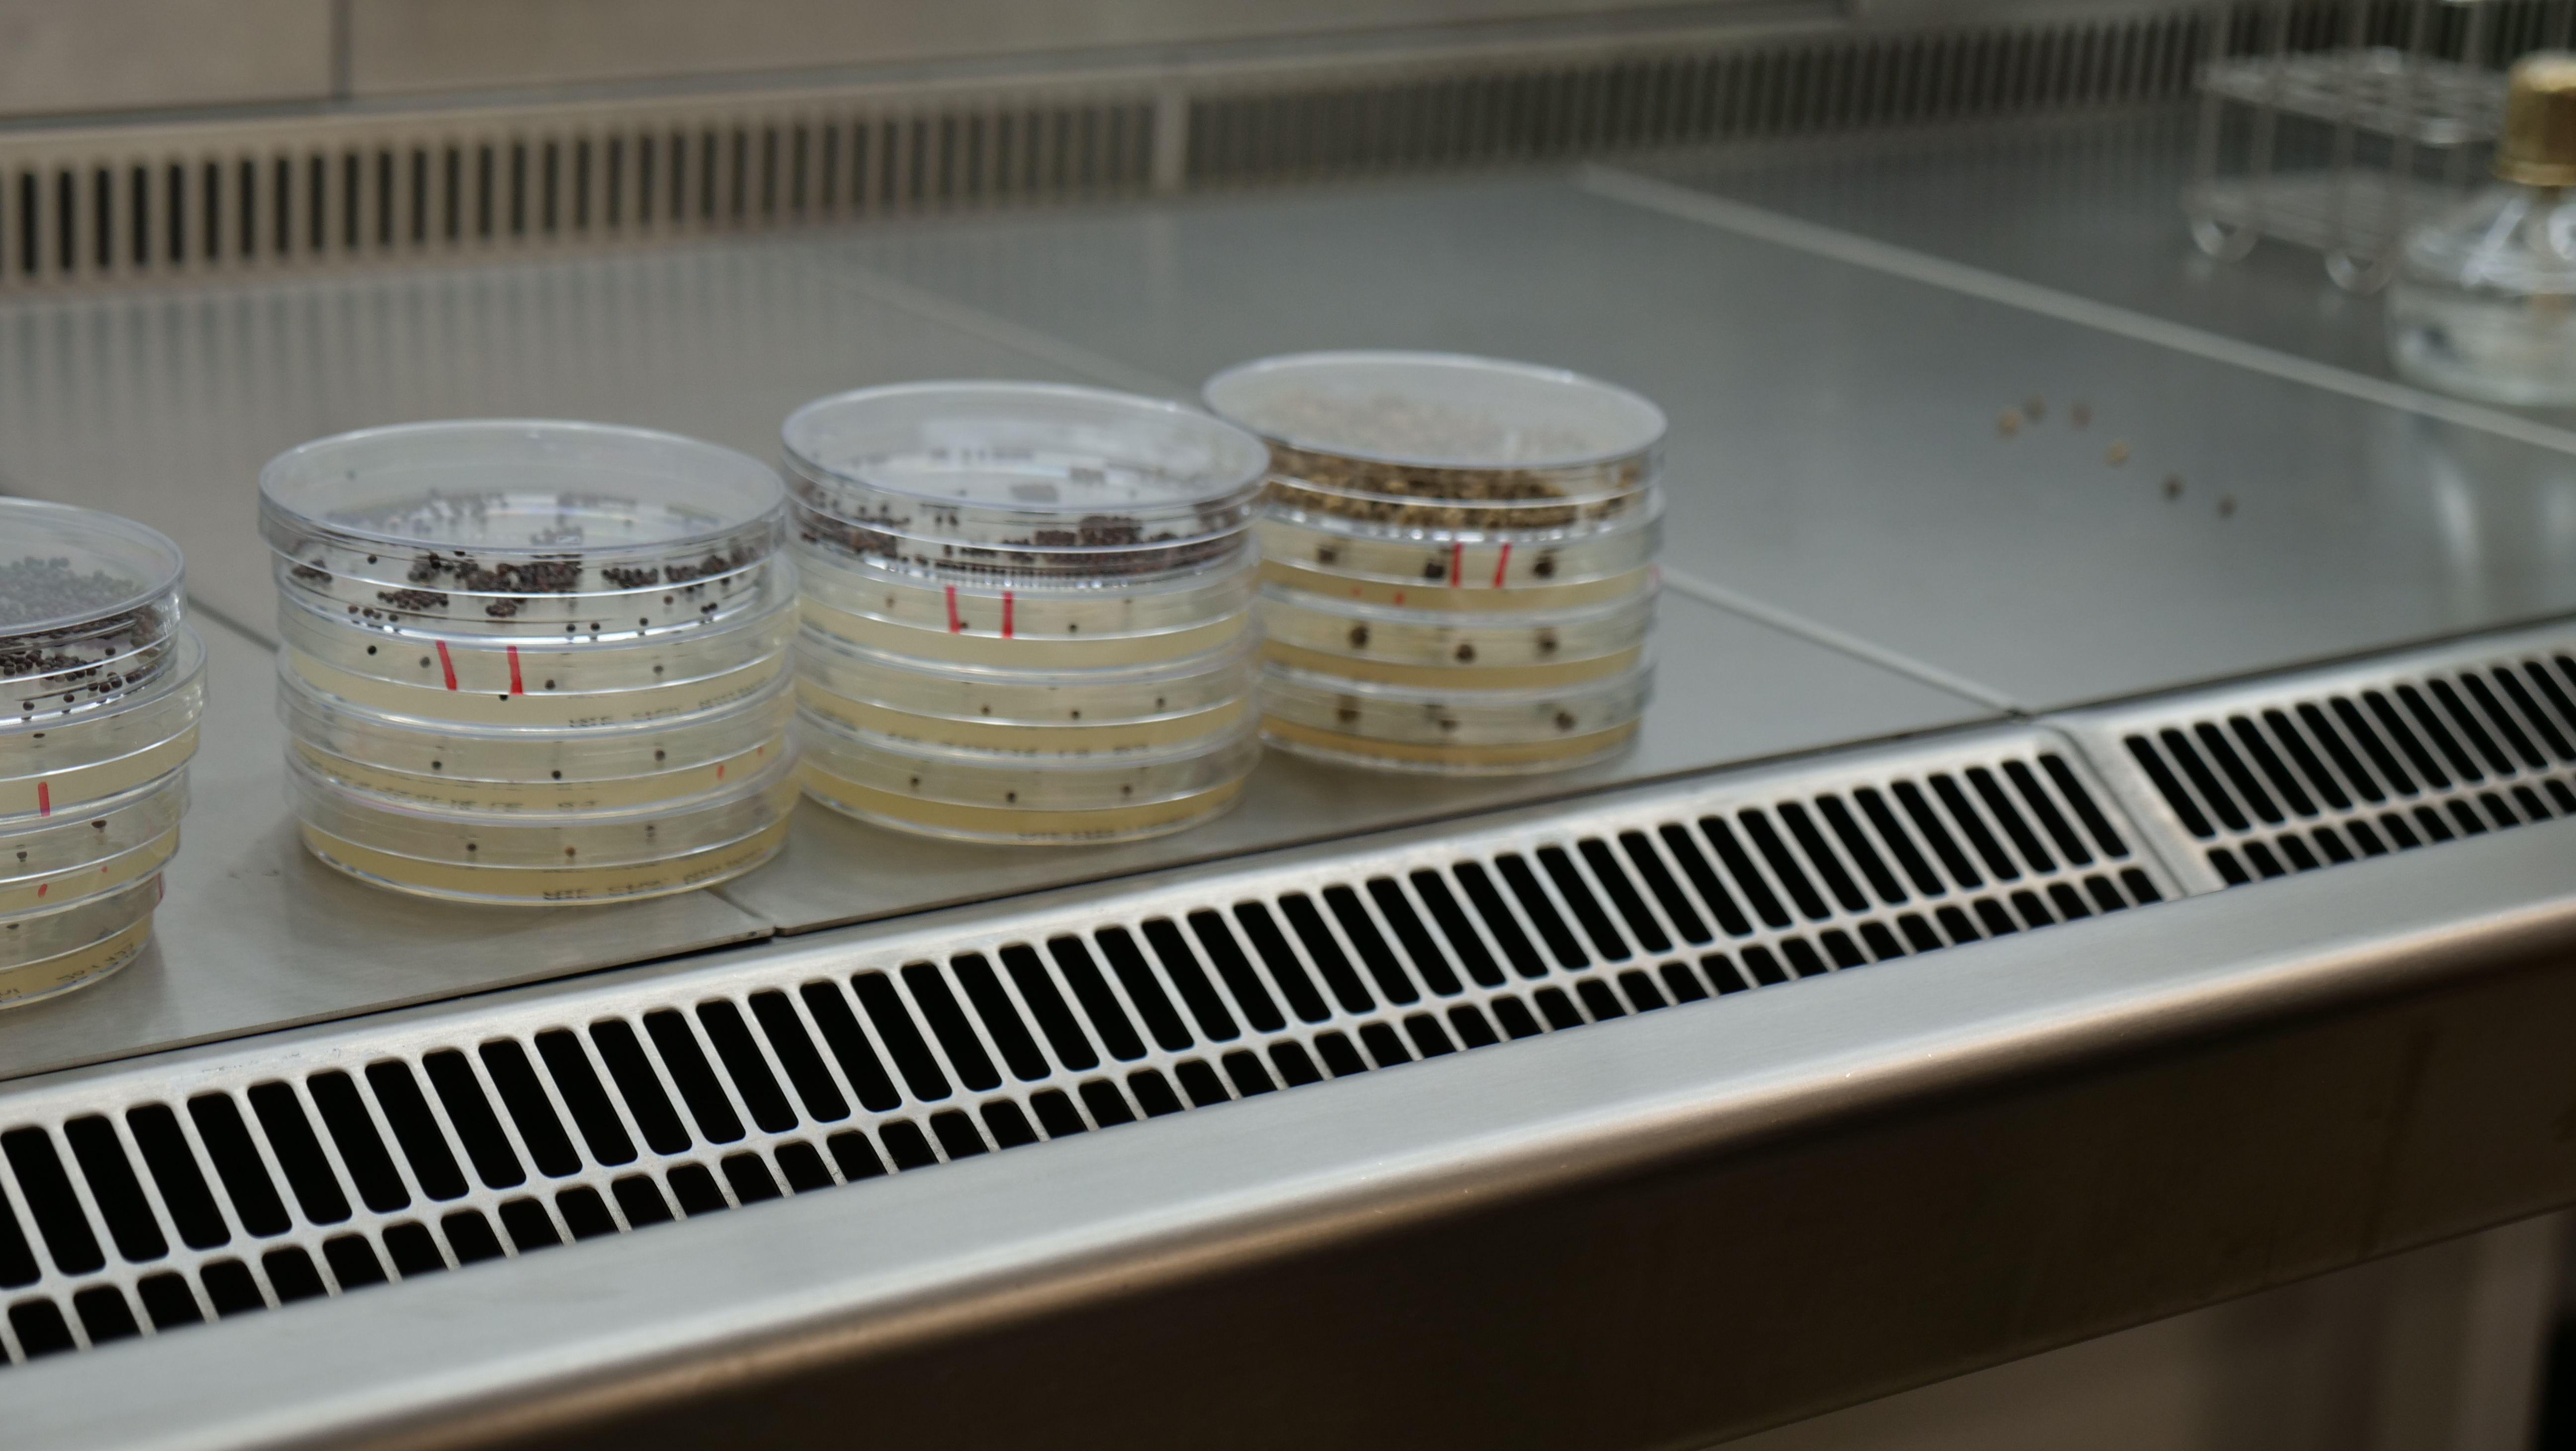
Agar

Drømmen om fremtidens landbrug i en betonhal

Mads Hagemann Petersen
Vertikalt landbrug er i sin spæde start, men er et bud på en bæredygtig produktion. I et industrikvarter nær København bliver der dyrket krydderurter, salat og kål uden brug af pesticider, med minimalt forbrug af vand, og LED-lyset får strøm fra vindmøller.
Et tæppe af grønne blade danner bølger i vinden, og kraftigt lys får grøntsagerne til at se ekstra sprøde ud.
Men planterne står ikke på en mark og lyses ikke op af solen. De er placeret i 14 etagers metalreoler i en betonhal i Taastrup. Her er ingen jord, for krydderurter, salater og grønkål er sat i lange rækker af plader.
Vand med præcist afstemte næringsmængder strømmer under planterne, og over dem sidder uendelige rækker af små LED-pærer. Lyset er justeret til et spekter for at skabe fotosyntese på den mest effektive måde.
Og vinden, den er skabt af store blæsere for at hvirvle luftens tilsatte CO2 rundt i hallen, så den ikke samler sig på gulvet. Desuden skal vinden blæse eventuelle bakterier væk fra planterne.
Nordic Harvest begyndte for fire år siden og producerer nu 250 ton grønt årligt. Størsteparten aftages af Salling Group, der henter varer to gange om uge, og sælger dem i Føtex og Bilka til samme pris som økologiske varer.
Målet er at udbygge den urbane farm, så produktion fra 2023 år er 1.000 ton årligt.

“Vores samlede ressourceforbrug er halvdelen af konventionelt landbrug og to tredjedel af økologisk landbrug, og vi bruger ikke nogen pesticider,” fortæller stifter og direktør Anders Riemann.
Han fik ideen, da han var ansat som økonom i Saxo Bank, men ville lave noget mere meningsfuldt. Han var frustreret over klimakrisen og ville gøre noget radikalt. Her tænkte han, at når det er så stort et problem, at der bliver fældet træer for at skaffe landbrugsjord, måtte en del af løsningen være at skabe landbrugsproduktion på meget mindre plads.
Anders Riemann så bogstaveligt talt lyset for otte år siden, da han på vej i metroen kiggede op i lamperne og funderede over, hvor effektive LED-pærer ville være til at skabe fotosyntese. Derefter gik han i gang med et intenst selvstudie for at sætte sig ind i teknik og planter – og endte med at sige sit job op for at dedikere sig til projektet.
Undervejs fik han blandt andet rådgivning fra Dickson D. Despommier, der er professor ved Columbia University og kendt for sit konceptuelle arbejde inden for vertikalt landbrug.
“Forbrugerne spiser jo ikke efter årstiden, selv om det ville være bedst klimamæssigt. Vertikalt landbrug er en af mulighederne for at kunne få varer af høj kvalitet hele året,” siger Anders Riemann.

Lys er den afgørende ressource
Energiforbruget til at producere maden er en begrænsende faktor i vertikalt landbrug.
Nordic Harvest producerer endnu kun krydderurter, salater og grønkål, hvor hele planten kan spises. Med eksempelvis tomater skal der først vokse en plante op, før det er muligt at høste tomater, og det koster ekstra strøm.
En fjerdedel af den totale udgift til at producere grøntsager hos Nordic Harvest går til energi.
“Lige nu bliver 25 pct. af energi i en LED-pære til lys, der kan skabe fotosyntese. Men udviklingen i effektiviteten betyder, at det øges 10 pct. om året. Så næste år er det 27 pct., og 30 pct. året efter. Det er det samme billede som med vindmøller, hvor teknologien er blevet mere og mere effektiv,” siger Anders Riemann.
“Og fordi vi renser og genbruger vandet, er vores forbrug af vand kun én liter pr. kilo plantemasse, mens det er 80 liter i drivhuse og 250 liter på land,” fortæller han.
Bakterier er en stor trussel
I produktionshallen går alle med hårnet, maske, dragt og blå futter ud over skoene. Og så meget som muligt af udstyret er af stål. Det skyldes, at bakterier er en af de største trusler i den pesticidfri produktion. Bakterier fra mennesker og frø kan sprede sig i vandet, der løber under planterne.
“Vi bruger økologiske frø, hvor det er et stort problem, at de kan bringe svamp med ind i produktionen. Derfor dypper vi dem i 50 grader varmt vand,” fortæller Anders Riemann.
På laboratoriet ved siden af produktionshallen bliver frøene undersøgt for spiringsevne og tjekket for bakterier på agarplader. Frøene renses i varmt vand og ved hjælp af UV-lys, som omdanner ilten i luften til ozon, der så dræber bakterierne.
Nordic Harvest bliver løbende afprøvet forskellige teknikker til at fjerne bakterier og svamp fra frøene.
“Vi håber at finde teknikker, der på længere sigt kan komme andre til gode, så det generelt vil være muligt at reducere pesticidforbruget i landbruget,” siger Anders Riemann.
I laboratoriet bliver der også produceret gødning ved at fermentere planterester. De bliver tilsat en bakterie og står og shaker i en uge i kolber for at få mikrosporstoffer med. Herefter bliver der tilsat mineraler og andre stoffer, der er gavnlige i dyrkningen. Den del udvikler Nordic Harvest hele tiden på.
Væsken med næringsstoffer bliver tilsat de store hvide vandtanke i produktionshallen.

Københavns Universitet er ved at undersøge, hvor sunde grøntsagerne fra Nordic Harvest er i forhold til fordelingen af stoffer i planterne.
“Studiet er ikke færdigt endnu, men det tyder på, at der er flere vitaminer og antioxidanter i vores grøntsager. Men det, vi laver her, er jo heller ikke unaturligt. Vi prøver netop at producere varer med mest mulig næringsværdi,” siger Anders Riemann.
CO2-tilskud fra Finland
Når man træder ind i produktionshallen, bliver man ramt af en fugtig varme. Luftfugtigheden er 80 pct., og temperaturen er 26 grader, som alle planterne kan klare.
CO2-indholdet i luften er tredoblet til 1.200 ppm for at give planterne tykkere membraner, så de er ekstra sprøde.
Anders Riemann plukker et par blade grønkål, der snart er klar til høst. De er under 10 cm lange og uden den kraftige stængel, der normalt er på grønkål. Smagen er også mere mild, og fibrene er finere, så strukturen minder mere om salat end kål.
Renheden af CO2’en i hallen er vigtig, så den ikke bare kan komme fra luften uden for bygningen. Den er leveret i gasflasker fra et finsk dieselraffinaderi, hvor CO2 samles op som et restprodukt, og Nordic Harvest betaler blot for transporten. Årsagen til at få det fra Finland er, at Nordic Harvest har et krav om en renhed af CO2 på 99,9997 pct.

Øget holdbarhed stopper madspild
Grøntsager fra Nordic Harvest behøver ikke blive vasket, fordi produktionen er uden jord, og der holdes strengt øje med bakterier. Det øger holdbarheden markant.
Nordic Harvest pakker grøntsagerne i en genlukkelig plastemballage, der er lavet af brugte colaflasker. Og de grønne blade holder blandt andet længere, fordi de ikke er blevet vasket, så der kan være fugt på dem.
“En pakke med vores salat kan holde sig 14 dage mod normalt tre til fem dage. Det giver mindre madspild og gør det nemt for forbrugerne, der ikke behøver at skylle de grønne blade,” siger Anders Riemann.
Varerne fra Nordic Harvest er 20 pct. dyrere i indkøb for supermarkederne end økologiske varer. Men fordi supermarkederne har mindre madspild på grønt fra hallen i Taastrup, kan de sælges til samme pris som økologiske varer i supermarkedet.
Han plukker en håndfuld blade af thaibasilikum. De har en kraftig og frisk smag. Det er en test til en ny kunde.
“Jeg er blevet kontaktet af en grossist, der importerer 400 kilo basilikum om ugen fra Asien. Men når det har ligget to dage i tolden for at blive tjekket, er halvdelen blevet for dårligt til at kunne bruges. Det er jo langt bedre at dyrke det lokalt.”
Ser sig som datavirksomhed
Vertikalt landbrug er et bud på fremtidens landbrug, mener Anders Riemann, og udviklingen kræver meget viden.
“Vi ser os som en datavirksomhed. Der bliver samlet en lang række data om planterne på alle de 336 hylder, så vi hele tiden kan blive bedre.”
Blandt de 35 ansatte er 10 akademikere. Der er 16 forskellige nationaliteter ansat, hvor nogle er kommet helt fra Brasilien og Canada.
Maskiner og udstyr bliver også løbende udviklet og bygget – fra høstmaskinen til den 25 meter lange vaskemaskine til plantepladerne. Der er ikke nogen færdige løsninger på det meste i vertikalt landbrug, så det er trial-and-error, og der er bump på vejen og maskiner, der går i stykker.
”I Danmark er vi et foregangsland inden for landbrug. Hvis vi får udviklet vertikalt landbrug, kan det kan blive en decideret industri, som også kan eksporteres. Hvis vi er dygtige nok, kan vi lave vertikalt landbrug i Afrika og andre tredjeverdenslande, så folk der kan flytte til byerne og få mættet deres maver med lokale varer,” siger Anders Riemann.
”Det helt store mål er, at vi skal kunne leve i langt bedre balance med naturen og give den videre til de næste generationer,” lyder hans vision.

Læs flere artikler om ...
Læs mere










